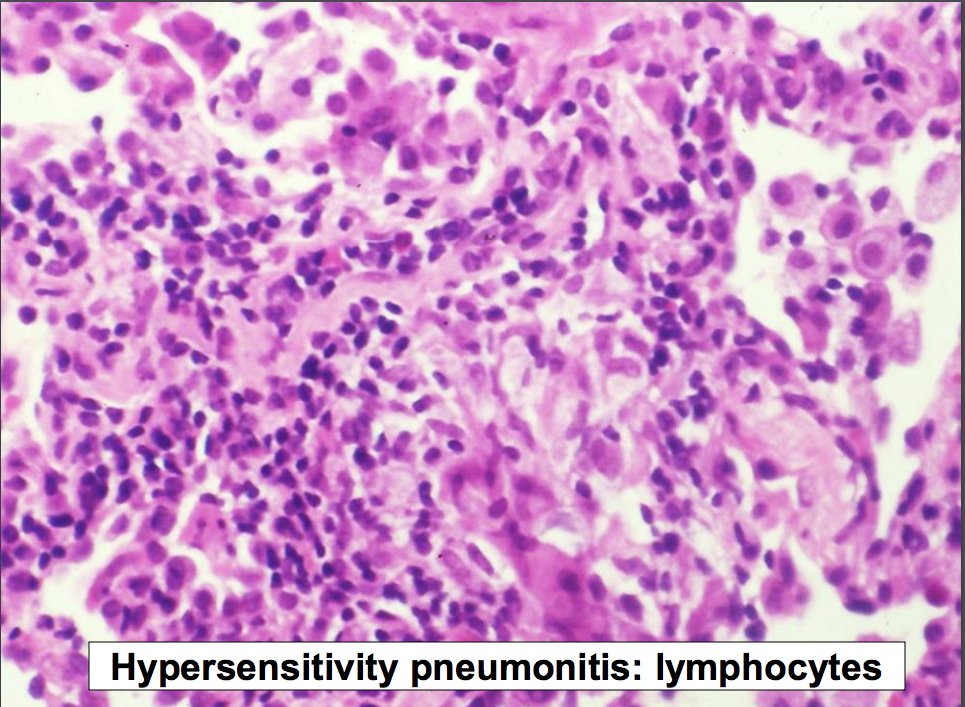

Acute Lung Injury
a condition characterized by:
1) an abrupt decline in respiratory function
2) bilateral infiltrates
3) reduced lung compliance
4) hypoxemia, in the
5) absence of heart failure. T
his condition may be caused by a wide variety of agents that diffusely injure the delicate lung parenchyma (e.g. sepsis, aspiration, infections, trauma, radiation, inhalation of toxic agents, drug reactions, etc.). Other times, the cause of ALI is idiopathic, for which the term “acute interstitial pneumonia (AIP)” is used.
Acute Respiratory Distress Syndrome
ARDS is a clinical syndrome characterized by severe acute respiratory failure, and is a manifestation of severe ALI.
*NOTE: Although all ARDS falls under the larger umbrella term of ALI, not all ALI is severe enough to result in ARDS.
4 Most Common Causes of ALi and ARDS
Diffuse Alveolar Damage
DAD is a pathologic term and is the histologic manifestation of severe acute lung injury (ALI), and generally occurs in association with clinical ARDS.
DAD Gross Appearance
Very heavy lungs, diffusely firm, and red-tan.

Microscopic Appearance DAD

Pathogenesis of DAD
The pathogenesis of DAD includes a combination of endothelial injury with endothelial activation, recruitment of neutrophils, accumulation of fluid in alveolar spaces with formation of hyaline membranes, and release of cytokines that perpetuate the inflammatory response
Treatment of ALI/ARDS
No proven treatments are available. Despite this grim reality, treatment usually includes:
Prognosis of ALI/ARDS
Restrictive Lung Disease Definition
A broad category of diffuse lung disease characterized by reduced expansion of lung parenchyma. This may occur in two settings:
1) diffuse diseases of the interstitium, such as pulmonary fibrosis (interstitial scarring), and
2) chest wall disease with normal lungs (e.g. obesity, pleural diseases, neuromuscular diseases).
• Over time, this usually results in decreased total lung volume, but airflow is normal or reduced proportionally.
Idiopathic Pulmonary Fibrosis
Clinical Characteristics of IPF
Pathogenesis of IPF
Gross Pathology of IPF
Gross pathology and the UIP pattern:

Microscopic Features of the UIP Pattern

*NOTE: Although IPF is characterized pathologically by the presence of fibrosis in a UIP pattern, this UIP pattern can also be seen in other nonidiopathic conditions. IPF by definition is idiopathic; if UIP is observed, a clinical diagnosis of IPF is only made after excluding other known causes of a UIP pattern!

Nonspecific Interstitial Pneumonia
Nonspecific interstitial pneumonia (NSIP) is a chronic fibrosing interstitial lung disease that lacks characteristics of the other wellcharacterized (specific) diseases. It can be idiopathic, or may occur in the setting of an underlying connective tissue disease.
Characteristics of NSIP


Cryptogenic Organizing Pneumonia
Cryptogenic organizing pneumonia (COP) is a restrictive lung disease of unknown (idiopathic or cryptogenic) cause, characterized by injury to the lung that results in filling of alveoli and terminal bronchioles by plugs of proliferating fibroblasts (“organization”).
Characteristics of COP


Connective Tissue Disease-Associated Interstitial Lung Disease
Certain connective tissue diseases can cause fibrosis of the lungs if they are poorly controlled, a feared complication of these disorders. When the lungs become involved in these disorders, fibrosis ensues that often has a pathologic pattern of either UIP or NSIP. Prevention or slowing of the disease is generally achieved by controlling the underlying connective tissue disease with steroids and immunomodulatory agents. Examples of connective tissue diseases that can cause lung fibrosis:
*NOTE: Rheumatoid arthritis can also produce an acute or chronic pleuritis, rheumatoid nodules in the lungs, DAD, bronchiolitis, and Caplan nodules (Caplan syndrome) when associated with silicosis or coal workers’ pneumoconiosis.
Drug Induced Lung Disease
Some drugs produce various forms of interstitial lung disease, particularly antineoplastic drugs.

Sarcoidosis
: Sarcoidosis is a multisystem granulomatous disease of unknown cause, characterized by granulomatous inflammation and fibrosis of affected organs; the lung is very commonly involved.

Characteristics of Sarcoidosis


Hypersensitivity Pneumonitis
Hypersensitivity pneumonitis (HP) is the term used for a group of related acute to chronic interstitial lung diseases, caused by heightened sensitivity and an inappropriate inflammatory reaction to inhaled organic antigens. Specific diseases are named after their etiologies (e.g., bird-fancier’s lung from exposure to avian protein antigens). Initial lesions lack mature fibrosis and are reversible, but mature fibrosis with a pathologic UIP pattern can occur with repeated attacks.
